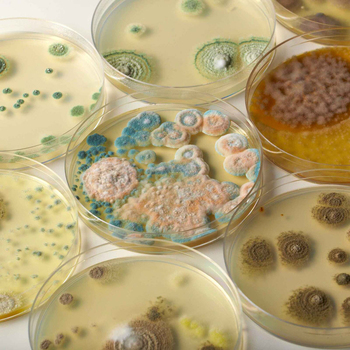
/assets/alt_3/HJ-4205.jpg?20240718134834
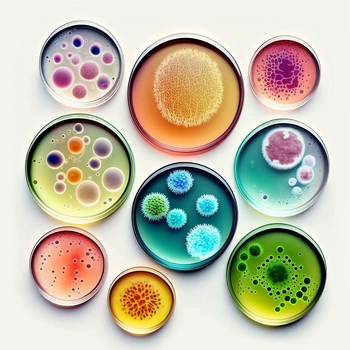
/assets/alt_7/HJ-4205.jpg?20240718134830

Heebie Jeebies Revolting Science Experiment Kids STEM Toy Kit 8+
or 4 payments of $9.25 with
 Learn more
Learn more
Reviews
Be The First To Review This Product!
Help other KG Electronic Pty Ltd users shop smarter by writing reviews for products you have purchased.
Heebie Jeebies Revolting Science Experiment Kids STEM Toy Kit 8+
Revolting Science is a gross science kit that allows kids to explore the fascinating world of bacteria with hands-on experiments. Featuring easy-to-follow instructions and high-quality materials, it is an ideal tool to introduce kids to microbial science in a fun and interactive way.
(HJ-4205)
Standard Consumer Warranty
| Model # | HJ-4205 |
| Barcode # | 9341570142051 |
| Brand | HEEBIE JEEBIES |
| Shipping Weight | 0.6000kg |
| Shipping Width | 0.300m |
| Shipping Height | 0.100m |
| Shipping Length | 0.200m |
| Shipping Cubic | 0.006000000m3 |
| Type | Experiments Kit |